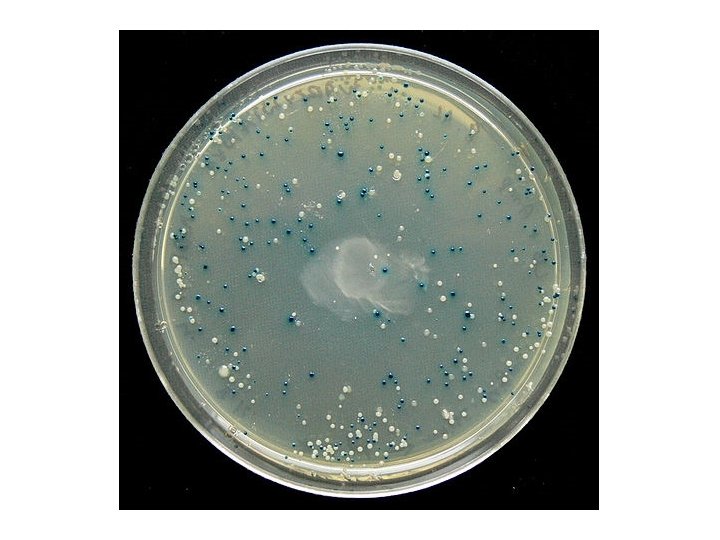

Bacterial cloning Especially of PCR product DNA PCR

Bacterial cloning Especially of PCR product DNA

PCR recap

PCR gel product

Gel 1 and 2 Gel 3 and 4

Cloning • Cloning is the way in which we can take a single molecule, and make lots of bacterial cells that contain an identical molecule. • These cells are clones, hence the name • This used to be the only way to amplify DNA. It is still by far the most accurate.


Plasmid vectors – circular, autonomous bacterial DNA

Cloning PCR products • When we amplify DNA using PCR, it is often necessary to “clone” this DNA • We do this in order to replicate it without errors • Also, by cloning a protein coding sequence into E. coli, we can then produce the protein in the bacterium.

The vector is made with a “T” overhang

Taq polymerase leaves an “A” overhang • Taq is thermostable DNA polymerase from Thermus aquaticus we used for PCR. • When Taq synthesizes a new strand, it always puts an extra “A” at the end • This can be useful, but note: other polymerases do not do this, only Taq polymerase

Restriction Endonucleases Also called restriction enzymes 1962: “molecular scissors” discovered in in bacteria E. coli bacteria have an enzymatic immune system that recognizes and destroys foreign DNA 3, 000 enzymes have been identified, around 200 have unique properties, many are purified and available commercially

Named for bacterial genus, species, strain, and type Example: Eco. R 1 Genus: Escherichia Species: coli Strain: R Order discovered: 1

Recognition sites have symmetry (palindromic) “Able was I, ere, I saw Elba” 5’-GGATCC-3’ Bam H 1 site: 3’-CCTAGG-5’

Restriction enzymes recognize specific 4 -8 bp sequences Some enzymes cut in a staggered fashion - “sticky ends” Eco. RI 5’…GAATTC… 3’ 3’…CTTAAG… 5’ Some enzymes cut in a direct fashion – “blunt ends” Pvu. II 5’…CAGCTG… 3’ 3’…GTCGAC… 5’


Why don’t bacteria destroy their own DNA with their restriction enzymes?

Methylation

Uses for Restriction Enzymes RFLP analysis (Restriction Fragment Length Polymorphism), CAPS (Cleaved Amplified Polymorphic Sequence) markers Cloning and construction of transgene “cassettes” DNA storage – libraries Genotyping by sequencing (“GBS”).

Restriction Enzymes for Cloning Corn DNA cleaved with Eco. RI Bacterial DNA cleaved with Eco. RI 5’-C-G-G-T-A-C-T-A-G-OH 3’-G-C-C-A-T-G-A-T-C-T-T-A-A-PO 4 + PO 4 -A-A-T-T-C-A-G-C-T-A-C-G-3’ HO-G-T-C-G-A-T-G-C-5’ Complementary base pairing 5’-A-C-G-G-T-A-C-T-A-G A-A-T-T-C-A-G-C-T-A-C-G-3’ 3’-T-G-C-C-A-T-G-A-T-C-T-T-A-A G-T-C-G-A-T-G-C-5’ + DNA Ligase, + r. ATP 5’-A-C-G-G-T-A-C-T-A-G-A-A-T-T-C-A-G-C-T-A-C-G-3’ 3’-T-G-C-C-A-T-G-A-T-C-T-T-A-A-G-T-C-G-A-T-G-C-5’ recombinant DNA molecule




Electroporation

i) When the electric field is applied, the ions move according to their charge. ii) Pathways are formed across the cell membrane allowing DNA to enter. iii) When the electric field is deactivated, the membrane heals.
- Slides: 25